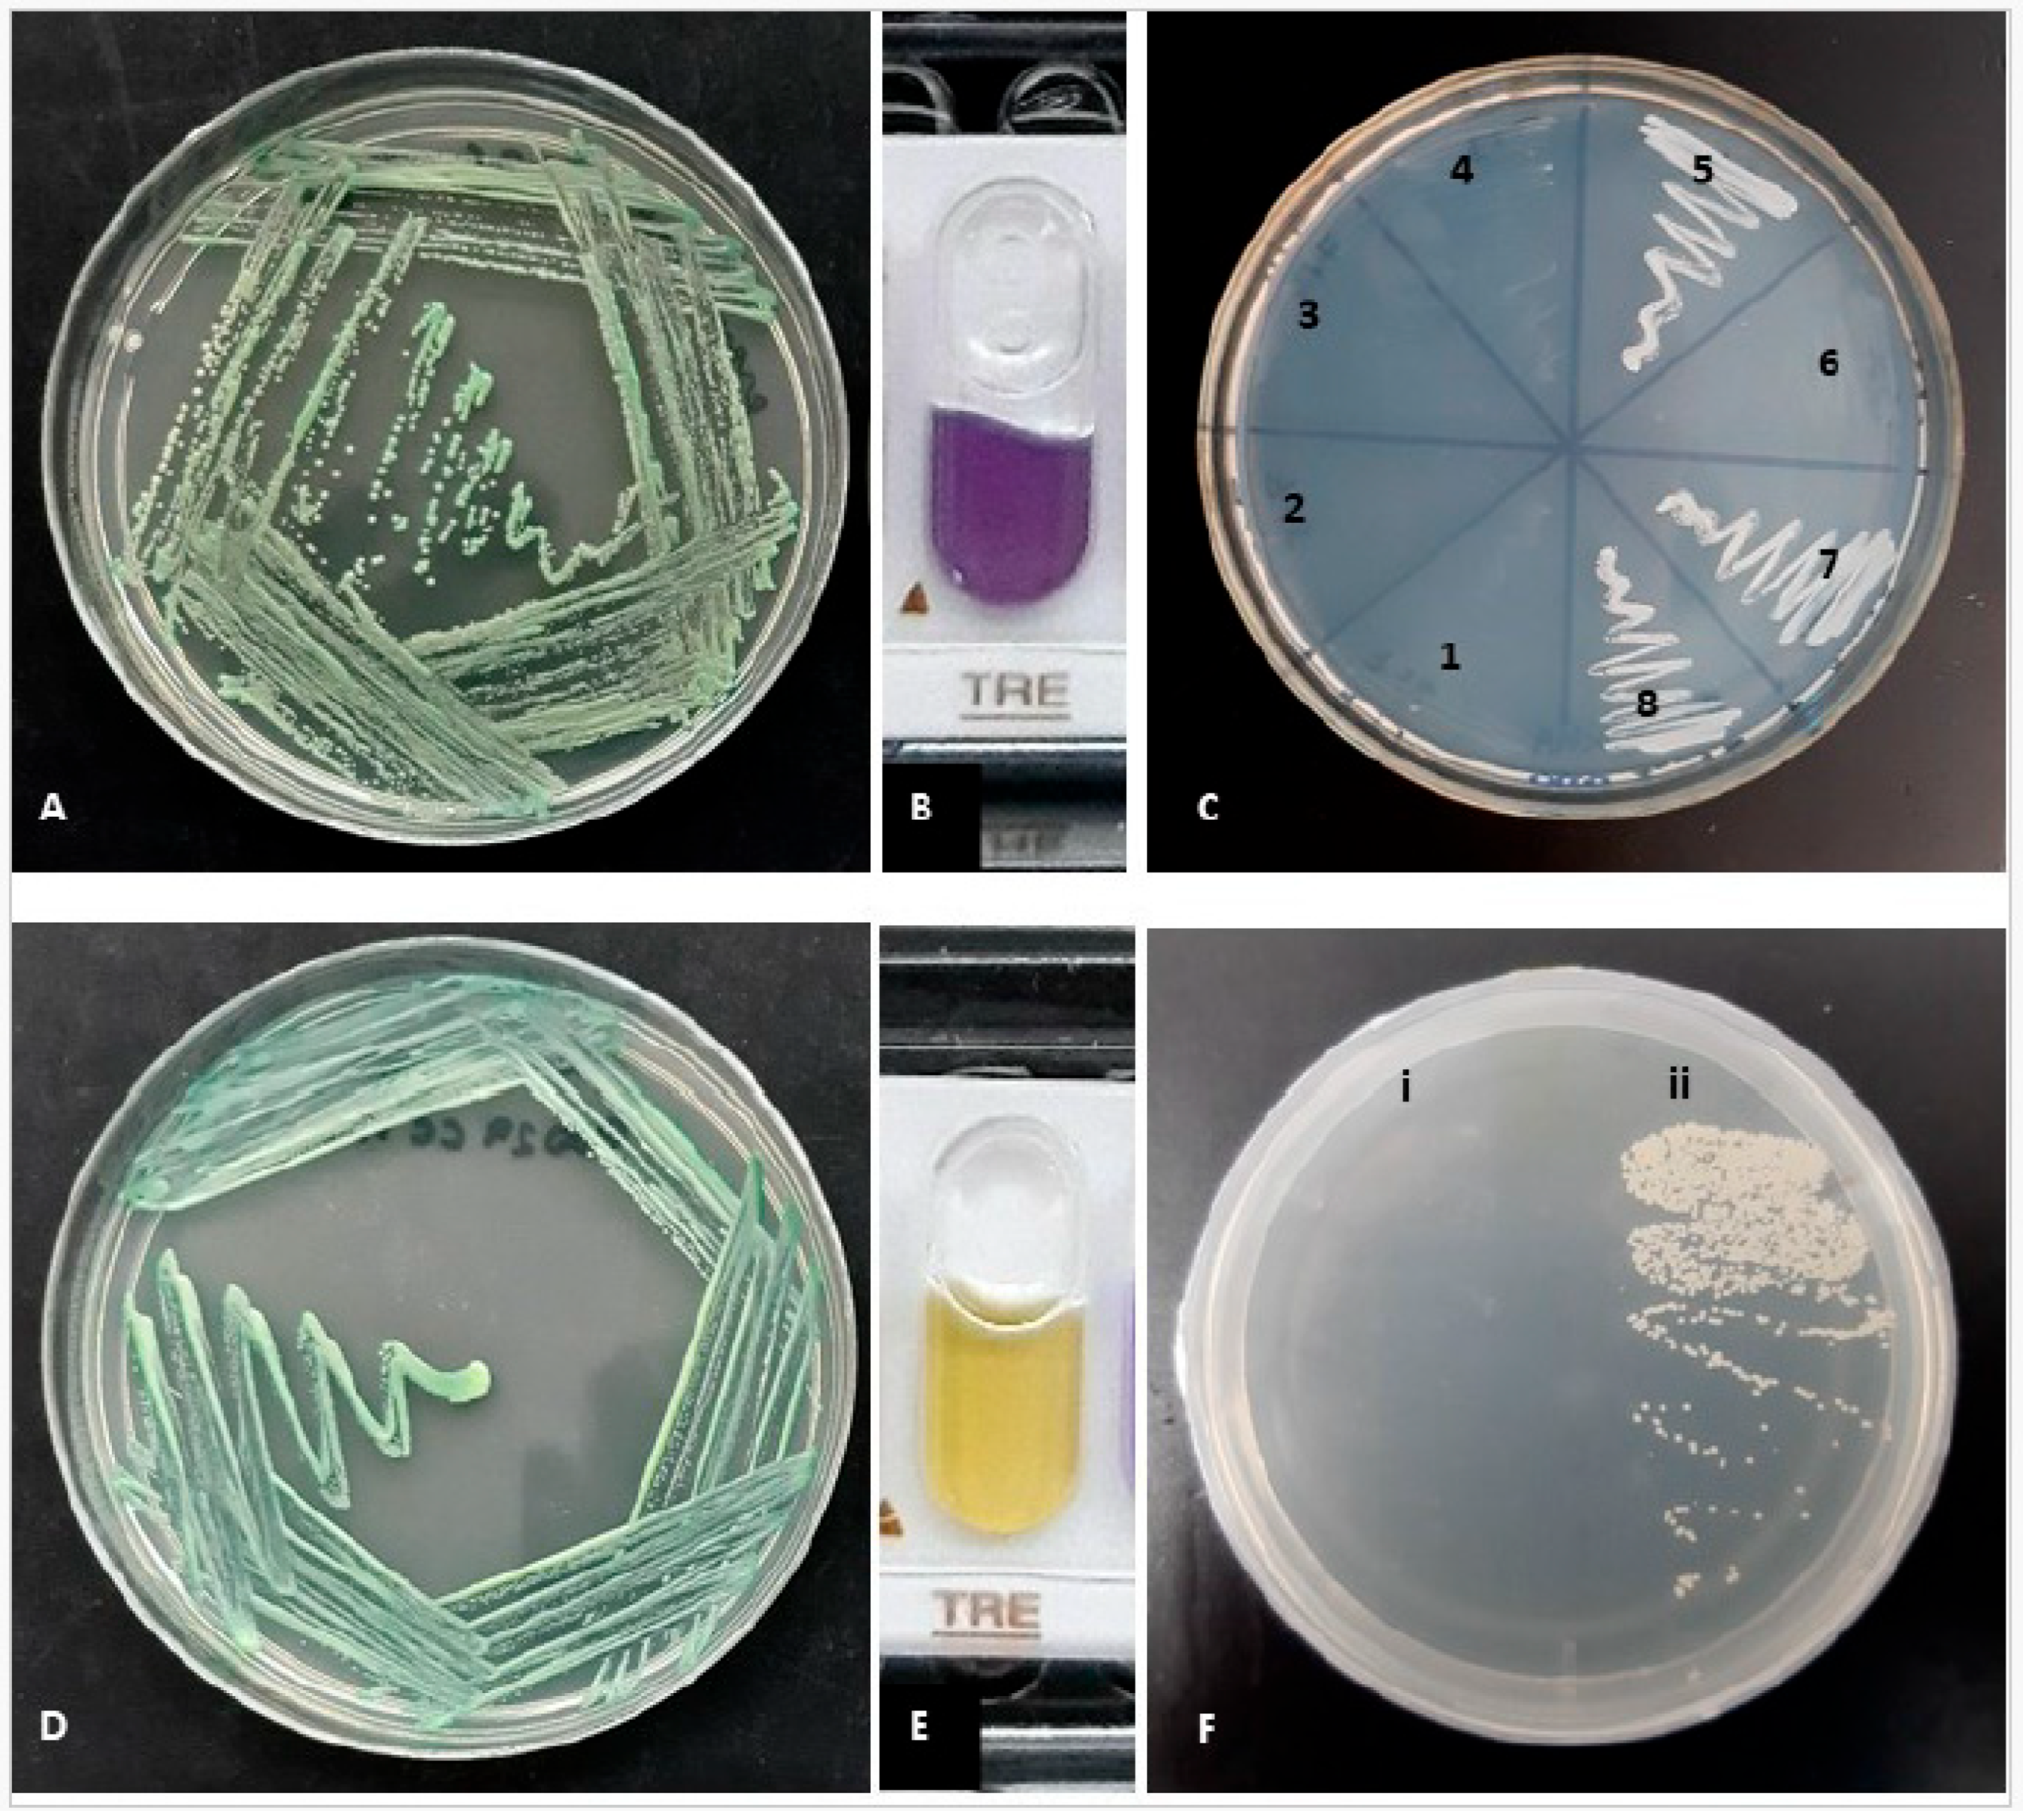
Antibiotics 14 00712 g001

Species Distribution, Characterization, and Antifungal Susceptibility Patterns of Candida Isolates Causing Oral and Vulvovaginal Candidiasis in Chile
Abstract
1. Introduction
2. Results
2.1. Phenotypic Identification
2.2. Molecular Identification
2.3. Susceptibility
3. Discussion
4. Materials and Methods
4.1. Phenotypic Identification
4.2. Molecular Identification
4.3. Susceptibility
5. Conclusions
Author Contributions
Funding
Institutional Review Board Statement
Informed Consent Statement
Data Availability Statement
Conflicts of Interest
References
- Ilkit, M.; Guzel, A.B. The epidemiology, pathogenesis, and diagnosis of vulvovaginal candidosis: A mycological perspective. Crit. Rev. Microbiol. 2011, 37, 250–261. [Google Scholar] [CrossRef] [PubMed]
- Ramadan, M.A.G.; Mustafa, L.S.; Jaber, M.A.; Ingafou, M.S. Detection of Species Diversity in Oral Fungi Colonization and Anti-Fungal susceptibility among Non-Oral Habit adult patients. Res. J. Pharm. Technol. 2023, 16, 5316–5322. [Google Scholar] [CrossRef]
- Saeed, A.A.R.; Al-Kolaibe, A.M.; Aladimi, A.A. Factors Predisposing to Oral Candidiasis Infection among Dental Clinic Patients in Taiz City, Yemen. Al Saeed. Univ. J Humanit Sci. 2024, 7, 71–93. [Google Scholar]
- Vila, T.; Sultan, A.S.; Montelongo-Jauregui, D.; Jabra-Rizk, M.A. Oral Candidiasis: A Disease of Opportunity. J. Fungi 2020, 6, 15. [Google Scholar] [CrossRef] [PubMed]
- Cadavid, A.M.H.; Gimenes, V.M.F.; Nico, M.M.S.; de Freitas, V.L.T.; Cavalcante, S.C.; Lourenço, S.V. Prevalence of Candida spp. in the oral cavity of patients admitted to the dermatology ward service of a level 3 hospital in São Paulo, Brazil. Res. Sq. 2022. [Google Scholar] [CrossRef]
- Gonçalves, B.; Ferreira, C.; Alves, C.T.; Henriques, M.; Azeredo, J.; Silva, S. Vulvovaginal candidiasis: Epidemiology, microbiology and risk factors. Crit. Rev. Microbiol. 2015, 42, 905–927. [Google Scholar] [CrossRef] [PubMed]
- Sobel, J.D. Vulvovaginal candidosis. Lancet 2007, 369, 1961–1971. [Google Scholar] [CrossRef] [PubMed]
- Gharehbolagh, S.A.; Fallah, B.; Izadi, A.; Ardestani, Z.S.; Malekifar, P.; Borman, A.M.; Mahmoudi, S.; Sturtevant, J. Distribution, antifungal susceptibility pattern and intra-Candida albicans species complex prevalence of Candida africana: A systematic review and meta-analysis. PLoS ONE 2020, 15, e0237046. [Google Scholar] [CrossRef] [PubMed]
- Mucci, M.J.; Cuestas, M.L.; Landanburu, M.F.; Mujica, M.T. Prevalence of Candida albicans, Candida dubliniensis and Candida africana in pregnant women suffering from vulvovaginal candidiasis in Argentina. Rev. Iberoam. De Micol. 2017, 34, 72–76. [Google Scholar] [CrossRef] [PubMed]
- Romeo, O.; Criseo, G. Candida africana and its closest relatives: Candida africana: The non-conforming strain. Mycoses 2011, 54, 475–486. [Google Scholar] [CrossRef] [PubMed]
- Coleman, D.; Sullivan, D.; Harrington, B.; Haynes, K.; Henman, M.; Shanley, D.; Bennett, D.; Moran, G.; McCreary, C.; O’Neill, L. Molecular and phenotypic analysis of Candida dubliniensis: A recently identified species linked with oral candidosis in HIV-infected and AIDS patients. Oral Dis. 1997, 3, S96–S101. [Google Scholar] [CrossRef] [PubMed]
- Cassone, A. Vulvovaginal Candida albicans infections: Pathogenesis, immunity and vaccine prospects. BJOG 2015, 122, 785–794. [Google Scholar] [CrossRef] [PubMed]
- Khan, Z.; Ahmad, S.; Chandy, R.; Joseph, L. A simple xylose-based agar medium for the differentiation of Candida dubliniensis and Candida albicans. Diagn. Microbiol. Infect. Dis. 2012, 72, 285–287. [Google Scholar] [CrossRef] [PubMed]
- Hashemi, S.E.; Shokohi, T.; Abastabar, M.; Aslani, N.; Ghadamzadeh, M.; Haghani, I. Species distribution and susceptibility profiles of Candida species isolated from vulvovaginal candidiasis, emergence of C. lusitaniae. Curr. Med. Mycol. 2019, 5, 26–34. [Google Scholar] [CrossRef] [PubMed]
- Gatica, M.J.L.; Goic, B.I.; Martínez, T.M.A.; Reid, S.d.O.I.; Céspedes, P.P.; Arias, E.M.C.; Ovalle, S.A.; Muster, O.H. Utilidad del agar Cromocandida para el diagnóstico diferencial de Candida spp. aisladas de muestras vaginales. Rev. Chil. Obstet. Ginecol. 2002, 67, 300–304. [Google Scholar] [CrossRef]
- Shokoohi, G.; Javidnia, J.; Mirhendi, H.; Rasekh-Jahromi, A.; Rezaei-Matehkolaei, A.; Ansari, S.; Maryami, F.; Goodarzi, S.; Romeo, O. Molecular identification and antifungal susceptibility profiles of Candida dubliniensis and Candida africana isolated from vulvovaginal candidiasis: A single-centre experience in Iran. Mycoses 2021, 64, 771–779. [Google Scholar] [CrossRef] [PubMed]
- Shan, Y.; Fan, S.; Liu, X.; Li, J. Prevalence of Candida albicans-closely related yeasts, Candida africana and Candida dubliniensis, in vulvovaginal candidiasis. Med. Mycol. 2014, 52, 636–640. [Google Scholar] [CrossRef] [PubMed]
- Theill, L.; Dudiuk, C.; Morano, S.; Gamarra, S.; Nardin, M.E.; Méndez, E.; Garcia-Effron, G. Prevalence and antifungal susceptibility of Candida albicans and its related species Candida dubliniensis and Candida africana isolated from vulvovaginal samples in a hospital of Argentina. Rev. Argent. de Microbiol. 2016, 48, 43–49. [Google Scholar] [CrossRef] [PubMed]
- Odds, F.C.; Bougnoux, M.-E.; Shaw, D.J.; Bain, J.M.; Davidson, A.D.; Diogo, D.; Jacobsen, M.D.; Lecomte, M.; Li, S.-Y.; Tavanti, A.; et al. Molecular Phylogenetics of Candida albicans. Eukaryot. Cell 2007, 6, 1041–1052. [Google Scholar] [CrossRef] [PubMed]
- Silveira-Gomes, F.; Sarmento, D.N.; Espírito-Santo, E.P.T.D.; Souza, N.d.O.; Pinto, T.M.; Marques-Da-Silva, S.H. Differentiation between Candida albicans and Candida dubliniensis using hypertonic Sabouraud broth and tobacco agar. Rev. da Soc. Bras. de Med. Trop. 2011, 44, 457–460. [Google Scholar] [CrossRef] [PubMed]
- Mahelová, M.; Růžička, F. Methods of Candida dubliniensis identification and its occurrence in human clinical material. Folia Microbiol. 2017, 62, 401–408. [Google Scholar] [CrossRef] [PubMed]
- Jan, A.; Bashir, G.; Fomda, B.A.; Khangsar, D.A.U.; Manzoor, M.; Kohli, A.; Reshi, S.; Suhail, M.; Choudhary, S.; Fatima, A. Hypertonic Xylose Agar Medium: A Novel Medium for Differentiation of Candida dubliniensis from Candida albicans. Indian J. Med. Microbiol. 2017, 35, 518–521. [Google Scholar] [CrossRef] [PubMed]
- Kirkpatrick, W.R.; Revankar, S.G.; Mcatee, R.K.; Lopez-Ribot, J.L.; Fothergill, A.W.; McCarthy, D.I.; Sanche, S.E.; Cantu, R.A.; Rinaldi, M.G.; Patterson, T.F. Detection of Candida dubliniensis in Oropharyngeal Samples from Human Immunodeficiency Virus-Infected Patients in North America by Primary CHROMagar Candida Screening and Susceptibility Testing of Isolates. J. Clin. Microbiol. 1998, 36, 3007–3012. [Google Scholar] [CrossRef] [PubMed]
- Kolekar, K.; Tambe, S.; Aderao, R.; Nayak, C. Chronic vulvovaginitis caused by Candida dubliniensis in an immunologically competent adult female. Int. J. STD AIDS 2018, 30, 90–93. [Google Scholar] [CrossRef] [PubMed]
- Sobel, J. Current Treatment Options for Vulvovaginal Candidiasis. Women’s Health 2005, 1, 253–261. [Google Scholar] [CrossRef] [PubMed]
- Tapia, C.V.; Hermosilla, G.; Fortes, P.; Alburquenque, C.; Bucarey, S.; Salinas, H.; Rodas, P.I.; Díaz, M.C.; Magne, F. Genotyping and Persistence of Candida albicans from Pregnant Women with Vulvovaginal Candidiasis. Mycopathologia 2016, 182, 339–347. [Google Scholar] [CrossRef] [PubMed]
- Hong, N.; Lei, Y.; Chen, H.; Chen, X.; Tsui, K.M.; Hu, D.; Liao, W.; Yan, L.; Zhang, H.; Zhao, R.; et al. Genotyping and Drug Resistance Profile of Clinical Isolates of Candida albicans from Vulvovaginal Candidiasis in the Eastern China. Mycopathologia 2022, 187, 217–224. [Google Scholar] [CrossRef] [PubMed]
- Gamarra, S.; Morano, S.; Dudiuk, C.; Mancilla, E.; Nardin, M.E.; Méndez, E.d.L.A.; Garcia-Effron, G. Epidemiology and Antifungal Susceptibilities of Yeasts Causing Vulvovaginitis in a Teaching Hospital. Mycopathologia 2014, 178, 251–258. [Google Scholar] [CrossRef] [PubMed]
- Mukasa, K.J.; Herbert, I.; Daniel, A.; Sserunkuma, K.L.; Joel, B.; Frederick, B. Antifungal Susceptibility Patterns of Vulvovaginal Candida species among Women Attending Antenatal Clinic at Mbarara Regional Referral Hospital, South Western Uganda. Br. Microbiol. Res. J. 2015, 5, 322–331. [Google Scholar] [CrossRef] [PubMed]
- Alves, S.H.; Milan, E.P.; Sant’ana, P.d.L.; Oliveira, L.O.; Santurio, J.M.; Colombo, A.L. Hypertonic sabouraud broth as a simple and powerful test for Candida dubliniensis screening. Diagn. Microbiol. Infect. Dis. 2002, 43, 85–86. [Google Scholar] [CrossRef] [PubMed]
- CLSI Supplement M27M44S; Performance Standards for Antifungal Susceptibility Testing of Yeasts. Clinical and Laboratory Standards Institute: Wayne, PA, USA, 2022.
- CLSI Supplement M57S; Epidemiological Cutoff Values for Antifungal Susceptibility Testing. Clinical and Laboratory Standards Institute: Wayne, PA, USA, 2022.

| Candida spp. | Interpretation | AND | AMB | MCF | CAS | 5-FC | POS | ITR | VRC | FLC |
|---|---|---|---|---|---|---|---|---|---|---|
| C. albicans (n = 90) | MIC range (μg/mL) | <0.015–0.12 | 0.12–0.25 | <0.008–0.03 | 0.03–0.12 | <0.06–0.5 | <0.08–0.5 | <0.015–0.5 | <0.008–1 | <0.12–16 |
| S/WT | 90 | 90 | 90 | 90 | 90 | 85 | 90 | 86 | 85 | |
| I/SDD | 0 | NA | 0 | 0 | NA | NA | NA | 2 | 2 | |
| R/non-WT | 0 | 0 | 0 | 0 | 0 | 5 * | 0 | 2 * | 3 * | |
| C. dubliniensis (n = 6) | MIC range (μg/mL) | <0.015–0.03 | 0.12–0.5 | <0.008–0.03 | 0.03–0.06 | <0.06–0.5 | <0.08–0.12 | <0.015–0.12 | <0.008–0.06 | <0.12–0.5 |
| S/WT | 6 | 6 | 6 | 6 | 6 | 6 | 6 | 6 | 6 | |
| I/SDD | 0 | NA | 0 | 0 | NA | NA | NA | 0 | 0 | |
| R/non-WT | 0 | 0 | 0 | 0 | 0 | 0 | 0 | 0 | 0 | |
| C. glabrata sensu stricto (n = 1) | MIC range (μg/mL) | 0.03 | 0.5 | 0.008 | 0.03 | 0.06 | 0.5 | 0.25 | 0.12 | 8 |
| S/WT | 1 | 1 | 1 | 1 | 1 | 1 | 1 | 1 | NA | |
| I/SDD | 0 | NA | 0 | 0 | NA | NA | NA | NA | 1 | |
| R/non-WT | 0 | 0 | 0 | 0 | 0 | 0 | 0 | 0 | 0 | |
| C. bracarensis (n = 1) | MIC range (μg/mL) | 0.12 | 0.12 | 0.015 | 0.06 | 0.06 | 0.25 | 0.12 | 0.06 | 4 |
| S/WT | 1 | 1 | 1 | 1 | 1 | 1 | 1 | 1 | NA | |
| I/SDD | 0 | NA | 0 | 0 | NA | NA | NA | NA | 1 | |
| R/non-WT | 0 | 0 | 0 | 0 | 0 | 0 | 0 | 0 | 0 | |
| C. tropicalis (n = 1) | MIC range (μg/mL) | 0.015 | 0.5 | 0.015 | 0.015 | 0.06 | 0.25 | 0.25 | 0.06 | 1 |
| S/WT | 1 | 1 | 1 | 1 | 1 | 0 | 1 | 1 | 1 | |
| I/SDD | 0 | NA | 0 | 0 | NA | NA | NA | 0 | 0 | |
| R/non-WT | 0 | 0 | 0 | 0 | 0 | 1 * | 0 | 0 | 0 | |
| C. lusitaniae (n = 1) | MIC range (μg/mL) | 0.12 | 0.12 | 0.06 | 0.12 | 0.06 | 0.03 | 0.06 | 0.015 | 1 |
| S/WT | 1 | 1 | 1 | 1 | 1 | 1 | 1 | NA | 1 | |
| I/SDD | NA | NA | NA | NA | NA | NA | NA | NA | NA | |
| R/non-WT | 0 | 0 | 0 | 0 | 0 | 0 | 0 | NA | 0 | |
| C. parapsilosis sensu stricto (n = 1) | MIC range (μg/mL) | 0.5 | 0.25 | 1 | 0.5 | 0.06 | 0.03 | 0.06 | 0.008 | 0.5 |
| S/WT | 1 | 1 | 1 | 1 | 1 | 1 | 1 | 1 | 1 | |
| I/SDD | 0 | NA | 0 | 0 | NA | NA | NA | 0 | 0 | |
| R/non-WT | 0 | 0 | 0 | 0 | 0 | 0 | 0 | 0 | 0 |
Disclaimer/Publisher’s Note: The statements, opinions and data contained in all publications are solely those of the individual author(s) and contributor(s) and not of MDPI and/or the editor(s). MDPI and/or the editor(s) disclaim responsibility for any injury to people or property resulting from any ideas, methods, instructions or products referred to in the content. |
© 2025 by the authors. Licensee MDPI, Basel, Switzerland. This article is an open access article distributed under the terms and conditions of the Creative Commons Attribution (CC BY) license (https://creativecommons.org/licenses/by/4.0/).
Share and Cite
Nahuelcura, F.; Duarte, E.Á. Species Distribution, Characterization, and Antifungal Susceptibility Patterns of Candida Isolates Causing Oral and Vulvovaginal Candidiasis in Chile. Antibiotics 2025, 14, 712. https://doi.org/10.3390/antibiotics14070712
Nahuelcura F, Duarte EÁ. Species Distribution, Characterization, and Antifungal Susceptibility Patterns of Candida Isolates Causing Oral and Vulvovaginal Candidiasis in Chile. Antibiotics. 2025; 14(7):712. https://doi.org/10.3390/antibiotics14070712
Chicago/Turabian StyleNahuelcura, Francisca, and Eduardo Álvarez Duarte. 2025. "Species Distribution, Characterization, and Antifungal Susceptibility Patterns of Candida Isolates Causing Oral and Vulvovaginal Candidiasis in Chile" Antibiotics 14, no. 7: 712. https://doi.org/10.3390/antibiotics14070712
APA StyleNahuelcura, F., & Duarte, E. Á. (2025). Species Distribution, Characterization, and Antifungal Susceptibility Patterns of Candida Isolates Causing Oral and Vulvovaginal Candidiasis in Chile. Antibiotics, 14(7), 712. https://doi.org/10.3390/antibiotics14070712







